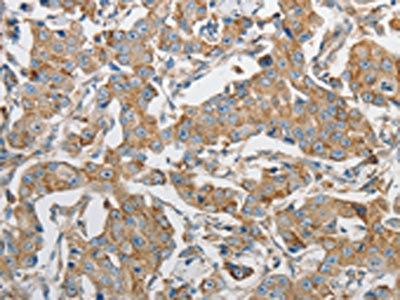

PRMT5 Antibody
-
中文名稱:PRMT5兔多克隆抗體
-
貨號:CSB-PA077190
-
規格:¥1100
-
圖片:
-
The image on the left is immunohistochemistry of paraffin-embedded Human breast cancer tissue using CSB-PA077190(PRMT5 Antibody) at dilution 1/20, on the right is treated with synthetic peptide. (Original magnification: ×200)
-
The image on the left is immunohistochemistry of paraffin-embedded Human tonsil tissue using CSB-PA077190(PRMT5 Antibody) at dilution 1/20, on the right is treated with synthetic peptide. (Original magnification: ×200)
-
Gel: 10%SDS-PAGE, Lysate: 40 μg, Lane 1-3: K562 cells, hela cells, 293T cells, Primary antibody: CSB-PA077190(PRMT5 Antibody) at dilution 1/400, Secondary antibody: Goat anti rabbit IgG at 1/8000 dilution, Exposure time: 2 minutes
-
-
其他:
產品詳情
-
Uniprot No.:
-
基因名:
-
別名:72 kDa ICln binding protein antibody; 72 kDa ICln-binding protein antibody; ANM5_HUMAN antibody; Histone synthetic lethal 7; S. cerevisiae; homolog of antibody; Histone-arginine N-methyltransferase PRMT5 antibody; HMT1 hnRNP methyltransferase like 5 antibody; HOMOLOG OF; SKB1 antibody; HRMT1L5 antibody; IBP72 antibody; Jak-binding protein 1 antibody; JBP 1 antibody; JBP1 antibody; PRMT 5 antibody; PRMT5 antibody; Protein arginine methyltransferase 5 antibody; Protein arginine N methyltransferase 5 antibody; Protein arginine N methyltransferase 5 N terminally processed antibody; Protein arginine N-methyltransferase 5 antibody; S. POMBE antibody; S. POMBE HOMOLOG OF; SKB1 antibody; SHK1 KINASE BINDING PROTEIN 1 antibody; Shk1 kinase binding protein 1 homolog antibody; Shk1 kinase-binding protein 1 homolog antibody; Shk1 kinase/binding protein 1; S. pombe; homolog of antibody; SKB 1 antibody; SKB1 antibody; SKB1 homolog antibody; SKB1: SKB1 homolog (S. pombe) antibody; SKB1Hs antibody
-
宿主:Rabbit
-
反應種屬:Human,Mouse,Rat
-
免疫原:Synthetic peptide of Human PRMT5
-
免疫原種屬:Homo sapiens (Human)
-
標記方式:Non-conjugated
-
抗體亞型:IgG
-
純化方式:Antigen affinity purification
-
濃度:It differs from different batches. Please contact us to confirm it.
-
保存緩沖液:-20°C, pH7.4 PBS, 0.05% NaN3, 40% Glycerol
-
產品提供形式:Liquid
-
應用范圍:ELISA,WB,IHC
-
推薦稀釋比:
Application Recommended Dilution ELISA 1:1000-1:2000 WB 1:200-1:1000 IHC 1:15-1:50 -
Protocols:
-
儲存條件:Upon receipt, store at -20°C or -80°C. Avoid repeated freeze.
-
貨期:Basically, we can dispatch the products out in 1-3 working days after receiving your orders. Delivery time maybe differs from different purchasing way or location, please kindly consult your local distributors for specific delivery time.
-
用途:For Research Use Only. Not for use in diagnostic or therapeutic procedures.
相關產品
靶點詳情
-
功能:Arginine methyltransferase that can both catalyze the formation of omega-N monomethylarginine (MMA) and symmetrical dimethylarginine (sDMA), with a preference for the formation of MMA. Specifically mediates the symmetrical dimethylation of arginine residues in the small nuclear ribonucleoproteins Sm D1 (SNRPD1) and Sm D3 (SNRPD3); such methylation being required for the assembly and biogenesis of snRNP core particles. Methylates SUPT5H and may regulate its transcriptional elongation properties. Mono- and dimethylates arginine residues of myelin basic protein (MBP) in vitro. May play a role in cytokine-activated transduction pathways. Negatively regulates cyclin E1 promoter activity and cellular proliferation. Methylates histone H2A and H4 'Arg-3' during germ cell development. Methylates histone H3 'Arg-8', which may repress transcription. Methylates the Piwi proteins (PIWIL1, PIWIL2 and PIWIL4), methylation of Piwi proteins being required for the interaction with Tudor domain-containing proteins and subsequent localization to the meiotic nuage. Methylates RPS10. Attenuates EGF signaling through the MAPK1/MAPK3 pathway acting at 2 levels. First, monomethylates EGFR; this enhances EGFR 'Tyr-1197' phosphorylation and PTPN6 recruitment, eventually leading to reduced SOS1 phosphorylation. Second, methylates RAF1 and probably BRAF, hence destabilizing these 2 signaling proteins and reducing their catalytic activity. Required for induction of E-selectin and VCAM-1, on the endothelial cells surface at sites of inflammation. Methylates HOXA9. Methylates and regulates SRGAP2 which is involved in cell migration and differentiation. Acts as a transcriptional corepressor in CRY1-mediated repression of the core circadian component PER1 by regulating the H4R3 dimethylation at the PER1 promoter. Methylates GM130/GOLGA2, regulating Golgi ribbon formation. Methylates H4R3 in genes involved in glioblastomagenesis in a CHTOP- and/or TET1-dependent manner. Symmetrically methylates POLR2A, a modification that allows the recruitment to POLR2A of proteins including SMN1/SMN2 and SETX. This is required for resolving RNA-DNA hybrids created by RNA polymerase II, that form R-loop in transcription terminal regions, an important step in proper transcription termination. Along with LYAR, binds the promoter of gamma-globin HBG1/HBG2 and represses its expression. Symmetrically methylates NCL. Methylates TP53; methylation might possibly affect TP53 target gene specificity. Involved in spliceosome maturation and mRNA splicing in prophase I spermatocytes through the catalysis of the symmetrical arginine dimethylation of SNRPB (small nuclear ribonucleoprotein-associated protein) and the interaction with tudor domain-containing protein TDRD6.
-
基因功能參考文獻:
- Expression of PRMT5 was significantly increased in human gastric cancer (GC) tissues compared with normal gastric mucosa. Multiple evidences suggested that PRMT5 repressed transcription of tumor suppressor IRX1 via recruitment of DNMT3A on promoter. PMID: 29802960
- PRMT5 may play a role from early oncogenesis through to the progression of oral squamous cell carcinoma , particularly in the aggressive mode of stromal invasion PMID: 29603824
- he phosphorylation of the MP inhibitory MYPT1(T850) and the regulatory PRMT5(T80) residues as well as the symmetric dimethylation of H2A/4 were elevated in human hepatocellular carcinoma and in other types of cancers. PMID: 28074910
- The polymerase-associated factor complex regulates Prmt5 to facilitate leukemic progression and is a potential therapeutic target for acute myeloid leukemias. PMID: 28945229
- our results indicated that PRMT5 overexpression in hepatocellular carcinoma (HCC)and colon cancer cells contributed to their acquisition of aggressive characteristics, such as invasiveness, thus presenting a promising therapeutic target for the treatment of these diseases PMID: 29749478
- PRMT5 as a key in vitro and in vivo regulator of breast cancer stem cells proliferation. PRMT5 epigenetically regulates FOXP1. PMID: 29262329
- Protein arginine methyltransferase 5 (PRMT5) was identified to be responsible for Eno-1 methylation. Overexpression of PRMT5 and caveolin-1 enhanced levels of membrane-bound extracellular Eno-1 and, conversely, pharmacological inhibition of PRMT5 attenuated Eno-1 cell-surface localization. PMID: 29501774
- A 3.7 A structure of PRMT5, solved in complex with regulatory binding subunit MEP50 (methylosome associated protein 50, WDR77, p44), by single particle (SP) cryo-Electron Microscopy (cryo-EM) using micrographs of particles that are visibly crowded and aggregated. The catalytic PRMT5 subunits form a core tetramer and the MEP50 subunits are arranged peripherally in complex with the PRMT5 N-terminal domain. PMID: 29518110
- These kinetic studies suggest a biochemical explanation for the interplay between PRMT5- and PRMT7-mediated methylation of the same substrate at different residues and also suggest a general model for regulation of PRMTs. PMID: 28874563
- Data indicate the significant potential of PRMT5 as a therapeutic target in pancreatic ductal adenocarcinoma (PDAC) and colorectal cancer (CRC). PMID: 28591716
- PRMT5 inhibited the interaction between CDK4 and CDKN2A and then activated the CDK4-RB-E2F pathway in hepatocellular carcinoma cells under glucose induction. PMID: 27708221
- Data suggest that the protein arginine methyltransferase 5 (PRMT5)-E2F1 transcription factor (E2F-1) pathway may act as a common target for exogenous lectins including Anguilla japonica lectin 1 (AJL1), and the cellular response to exogenous AJL1 may suggest a novel agent for cancer gene therapy. PMID: 26990556
- These results could be helpful in discovering new potent and specific inhibitors of PRMT5, as well as in designing mutant residue assay to modulate the catalytic activity of PRMT5. PMID: 29154828
- PRMT1 inhibition prevents gastric cancer progression by downregulating eIF4E and targeting type II PRMT5. PMID: 28987382
- Data indicate that ZNF326 is an interaction partner and substrate of the PRMT5/WDR77 complex. PMID: 28977470
- ERG signaling in prostate cancer is driven through PRMT5-dependent methylation of the androgen receptor. PMID: 27183006
- SFN treatment of tumors results in reduced MEP50 level and H4R3me2s formation, confirming that that SFN impacts this complex in vivo. These studies suggest that the PRMT5/MEP50 is required for tumor growth and that reduced expression of this complex is a part of the mechanism of SFN suppression of tumor formation. PMID: 28854561
- High nuclear PRMT5 expression is associated with oropharyngeal squamous cell carcinoma. PMID: 28107179
- High PRMT5 expression is associated with prostate cancer. PMID: 27546619
- Results provide evidence that PRMT5 and p44 regulate gene expression of growth and anti-growth factors to promote lung tumorigenesis. PMID: 27480244
- PRMT5 regulates internal ribosome entry site-dependent translation via methylation of hnRNP A1. PMID: 28115626
- PRMT5 knockdown reduces growth, survival, and colony formation of chronic myelogenous leukemia CD34+ cells. PMID: 27643437
- Methylation of RUVBL1 by the arginine methyltransferase PRMT5 is required for homologous recombination-mediated double-strand break repair by promoting TIP60-mediated histone H4K16 acetylation. PMID: 28238654
- findings show that PRMT5 is an important modulator of CD4(+) T cell expansion; PRMT5 was transiently upregulated during maximal proliferation of mouse and human memory Th cells; data implicate PRMT5 in the regulation of adaptive memory Th cell responses PMID: 28087667
- Results provide evidence that PRMT5 differentially regulates self-renewal, survival and proliferation of primary glioblastoma neurosphere cells (GBMNS) PMID: 27292259
- PRMT5 regulated the production of inflammatory factors, cell proliferation, migration and invasion of rheumatoid arthritis fibroblast-like synoviocytes. PMID: 27860244
- The C-terminal motif of PRMT5 is required for plasma membrane association, and loss of this switching capacity is not compatible with life. This signaling phenomenon was recently reported for the HPV E6 oncoprotein but has not yet been observed for mammalian proteins PMID: 28031468
- our results indicate that PRMT5 may act as a putative oncogene in hepatocellular carcinoma PMID: 28101581
- high expression of PRMT5 in primary and metastatic breast cancer lesions and indicated its function in cell proliferation, cell cycle progression, and apoptosis. PMID: 28381188
- Study showed that PRMT5 mRNA levels were significantly higher in gastric cancer (GC) tissues and were independent of tumor depth, differentiation and lymph node metastasis. Findings indicate that PRMT5 acts as an oncogene in GC by enhancing the malignant phenotype of a cancer cell line. PMID: 27315569
- PRMT5 as an ASK1-binding protein.PRMT5 mediates arginine methylation of ASK1. PMID: 26912789
- methionine adenosyltransferase II alpha (MAT2A), and the arginine methyltransferase, PRMT5, as vulnerable enzymes in cells with MTAP deletion. PMID: 27068473
- Our results indicate that PRMT5 is a marker of poor prognosis in NPC patients. PRMT5 promoted the radioresistance of NPC cells via targeting FGFR3, at least partly if not totally. PMID: 26708443
- Data show that Omomyc protein co-localized with proto-oncogene protein c-myc (c-Myc), protein arginine methyltransferase 5 (PRMT5) and histone H4 H4R3me2s-enriched chromatin domains. PMID: 26563484
- PRMT5 expression was upregulated during HTLV-1-mediated T-cell transformation. PMID: 26729154
- Increased PRMT5 activity enhanced acute myeloid leukemia growth. PMID: 26536822
- arginine residues within the third intracellular loop of the D2 dopamine receptor were methylated by protein arginine methyltransferase 5 (PRMT5) PMID: 26554819
- high nuclear expression of Protein arginine methyltransferase-5 is a potentially useful marker for estimating submucosal invasion of early colorectal carcinomas in endoscopically resected specimens PMID: 26248553
- Findings provide new evidence that PRMT5 plays an important role in CRC pathogenesis through epigenetically regulating arginine methylation of oncogenes such as eIF4E and FGFR3. PMID: 26078354
- PRMT5-induced methylation prevented phosphorylation of SREBP1a on S430 by GSK3beta PMID: 26759235
- PRMT5 plays an important role in human hepatocellular carcinoma growth via the downregulation of beta-catenin PMID: 26541651
- PRMT5 gene is silencing gene expression by histone arginine methylation in keratinocytes. PMID: 26763441
- PRMT5 co-localizes with RASSF1A on stabilized microtubules.RASSF1A promotes the translocation of cytosolic PRMT5 to microtubules. PMID: 26482848
- UHRF1 could form a complex with PRMT5 to contribute to the endometrial carcinogenesis. PMID: 26597461
- these findings reveal PRMT5 as a potential vulnerability across multiple cancer lineages augmented by a common "passenger" genomic alteration. PMID: 26912360
- methylthioadenosine accumulation in 5-methylthioadenosine phosphorylase-deleted cancers creates a hypomorphic PRMT5 state that is selectively sensitized toward further PRMT5 inhibition. PMID: 26912361
- PRMT5- mediated symmetric arginine dimethylation is attenuated by mutant huntingtin and is impaired in Huntington's disease. PMID: 25927346
- PRMT5 is required for lymphomagenesis triggered by multiple oncogenic drivers PMID: 25582697
- The novel PRMT5S likely contributes to the observed diverse effects of PRMT5 in cells. PMID: 26151339
- These studies implicate PRMT5 in a novel mode of MYCN post-translational regulation. PMID: 25475372
顯示更多
收起更多
-
亞細胞定位:Cytoplasm. Nucleus. Chromosome. Golgi apparatus.
-
蛋白家族:Class I-like SAM-binding methyltransferase superfamily, Protein arginine N-methyltransferase family
-
組織特異性:Ubiquitous.
-
數據庫鏈接:
Most popular with customers
-
-
YWHAB Recombinant Monoclonal Antibody
Applications: ELISA, WB, IHC, IF, FC
Species Reactivity: Human, Mouse, Rat
-
Phospho-YAP1 (S127) Recombinant Monoclonal Antibody
Applications: ELISA, WB, IHC
Species Reactivity: Human
-
-
-
-
-